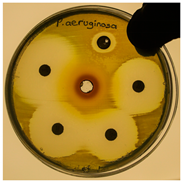

The Nephroprotective Effect of Punica granatum Peel Extract on LPS-Induced Acute Kidney Injury
Abstract
1. Introduction
2. Materials and Methods
2.1. The Procurement and Extraction of P. granatum
2.2. HPLC Analysis
2.3. Animal Experiment and Drug Administration
2.4. Biochemical Analysis
2.4.1. Determination of Serum Blood Urea Nitrogen (BUN), Creatinine (Cr) and C-Reactive Protein (CRP) Levels
2.4.2. Determination of Tissue Thiobarbituric Acid Reactive Substances (TBARS) and Reduced Glutathione (GSH) Levels
2.5. Histopathological Analysis
2.6. Immunohistochemical (IHC) Analysis
2.7. Semi-Quantitative Analysis
2.8. Antibacterial Assay
2.8.1. Agar Well Diffusion Method
2.8.2. MIC (Minimum Inhibitory Concentration) Assay
2.9. Statistical Tests
3. Results
3.1. HPLC Analysis
3.2. Biochemical Results
3.2.1. BUN, Cr and CRP Levels
3.2.2. TBARS and GSH Levels
3.3. Histopathological Analysis
3.4. IHC Analysis
3.4.1. TLR4 Positivity
3.4.2. NF-κB/p65 Positivity
3.5. Antibacterial Assay
3.5.1. Agar Well Diffusion Method
3.5.2. MIC Assay
4. Discussion
5. Conclusions
Author Contributions
Funding
Institutional Review Board Statement
Informed Consent Statement
Data Availability Statement
Conflicts of Interest
References
- Caraballo, C.; Jaimes, F. Organ dysfunction in sepsis: An ominous trajectory from infection to death. Yale J. Biol. Med. 2019, 92, 629–640. [Google Scholar] [PubMed]
- Peerapornratana, S.; Manrique-Caballero, C.L.; Gómez, H.; Kellum, J.A. Acute kidney injury from sepsis: Current concepts, epidemiology, pathophysiology, prevention and treatment. Kidney Int. 2019, 96, 1083–1099. [Google Scholar] [CrossRef] [PubMed]
- Fleischmann, C.; Scherag, A.; Adhikari, N.K.J.; Hartog, C.S.; Tsaganos, T.; Schlattmann, P.; Angus, D.C.; Reinhart, K. Assessment of global incidence and mortality of hospital-treated sepsis. Current estimates and limitations. Am. J. Respir. Crit. Care Med. 2016, 193, 259–272. [Google Scholar] [CrossRef]
- Bellomo, R.; Kellum, J.A.; Ronco, C.; Wald, R.; Martensson, J.; Maiden, M.; Bagshaw, S.M.; Glassford, N.J.; Lankadeva, Y.; Vaara, S.T. Acute kidney injury in sepsis. Intensive Care Med. 2017, 43, 816–828. [Google Scholar] [CrossRef]
- Altintas, N.D. Sepsis and Kidneys. Turk. Klin. Intensive Care-Spec. Top. 2021, 7, 56–61. [Google Scholar]
- Khwaja, A. KDIGO clinical practice guidelines for acute kidney injury. Nephron Clin. Pract. 2012, 120, 179–184. [Google Scholar] [CrossRef] [PubMed]
- Li, X.Q.; Liu, H.; Meng, Y.; Yin, H.Y.; Gao, W.Y.; Yang, X.; Xu, D.S.; Cai, X.D.; Guan, Y.; Lerman, L.O.; et al. Critical roles of cytokine storm and secondary bacterial infection in acute kidney injury development in COVID-19: A multi-center retrospective cohort study. J. Med. Virol. 2021, 93, 6641–6652. [Google Scholar] [CrossRef]
- Hoste, E.A.J.; Bagshaw, S.M.; Bellomo, R.; Cely, C.M.; Colman, R.; Cruz, D.N.; Edipidis, K.; Forni, L.G.; Gomersall, C.D.; Govil, D. Epidemiology of acute kidney injury in critically ill patients: The multinational AKI-EPI study. Intensive Care Med. 2015, 41, 1411–1423. [Google Scholar] [CrossRef]
- Kumar, N.R.; Balraj, T.A.; Kempegowda, S.N.; Prashant, A. Multidrug-resistant sepsis: A critical healthcare challenge. Antibiotics 2024, 13, 46. [Google Scholar] [CrossRef]
- Chun, K.; Syndergaard, C.; Damas, C.; Trubey, R.; Mukindaraj, A.; Qian, S.; Jin, X.; Breslow, S.; Niemz, A. Sepsis pathogen identification. J. Lab. Autom. 2015, 20, 539–561. [Google Scholar] [CrossRef]
- Ventola, C.L. The antibiotic resistance crisis: Part 1: Causes and threats. P.T. 2015, 40, 277–283. [Google Scholar] [PubMed]
- O’Neill, J. Tackling Drug-Resistant Infections Globally: Final Report and Recommendations; Wellcome Trust and HM Government: London, UK, 2016. [Google Scholar]
- Dhara, A.K.; Mandal, S.C. Role of Herbal Medicines: Management of Lifestyle Diseases; Springer Nature: Berlin/ Heidelberg, Germany, 2023. [Google Scholar]
- Kamboj, V.P. Herbal medicine. Curr. Sci. 2020, 78, 35–39. [Google Scholar]
- Deans, S.; Ritchie, G. Antibacterial properties of plant essential oils. Int. J. Food Microbiol. 1987, 5, 165–180. [Google Scholar] [CrossRef]
- Batool, K.; Sultana, S.; Akhtar, N.; Asif, H.M.; Akhtar, N.; Ahmad, K.; Owais, A. Medicinal plants combating against human pathogens: A review. Int. J. Biotechnol. Food Sci. 2018, 6, 42–51. [Google Scholar]
- Gonzalez Gonzalez, G.M.; Esparza Gonzalez, S.C.; Nery Flores, S.D.; Morlett Chavez, J.A.; Ascacio Valdes, J.A.; Flores Gallegos, A.C.; Saenz Galindo, A.; Rodriguez Herrera, R. Anticancer activity of polyphenolic Punica granatum peel extracts obtained by hybrid ultrasound microwave assisted extraction: Evaluation on HeLa and HepG2 cells. Environ. Qual. Manag. 2023, 33, 295–304. [Google Scholar] [CrossRef]
- Segar, H.M.; Gani, S.A.; Khayat, M.E.; Rahim, M.B.H. Antioxidant and Antidiabetic Properties of Pectin Extracted from Pomegranate (Punica granatum) Peel. J. Biochem. Microbiol. Biotechnol. 2023, 11, 35–40. [Google Scholar] [CrossRef]
- Al-Zoreky, N.S. Antimicrobial activity of pomegranate (Punica granatum L.) fruit peels. Int. J. Food Microbiol. 2009, 134, 244–248. [Google Scholar] [CrossRef] [PubMed]
- Qnais, E.Y.; Elokda, A.S.; Abu Ghalyun, Y.Y.; Abdulla, F.A. Antidiarrheal Activity of the Aqueous extract of Punica granatum (Pomegranate) peels. Pharm. Biol. 2007, 45, 715–720. [Google Scholar] [CrossRef]
- Dahham, S.S.; Ali, M.N.; Tabassum, H.; Khan, M. Studies on antibacterial and antifungal activity of pomegranate (Punica granatum L.). Am. Eurasian J. Agric. Environ. Sci. 2010, 9, 273–281. [Google Scholar]
- Marques, L.C.F.; Pinheiro, A.J.M.C.R.; Araújo, J.G.G.; de Oliveira, R.A.G.; Silva, S.N.; Abreu, I.C.; de Sousa, E.M.; Fernandes, E.S.; Luchessi, A.D.; Silbiger, V.N. Anti-inflammatory effects of a pomegranate leaf extract in LPS-induced peritonitis. Planta Med. 2016, 82, 1463–1467. [Google Scholar] [CrossRef]
- Mastrogiovanni, F.; Mukhopadhya, A.; Lacetera, N.; Ryan, M.T.; Romani, A.; Bernini, R.; Sweeney, T. Anti-inflammatory effects of pomegranate peel extracts on in vitro human intestinal caco-2 cells and ex vivo porcine colonic tissue explants. Nutrients 2019, 11, 548. [Google Scholar] [CrossRef]
- Cerdá, B.; Cerón, J.J.; Tomás-Barberán, F.A.; Espín, J.C. Repeated oral administration of high doses of the pomegranate ellagitannin punicalagin to rats for 37 days is not toxic. J. Agric. Food Chem. 2003, 51, 3493–3501. [Google Scholar] [CrossRef] [PubMed]
- Guo, C.; Yang, J.; Wei, J.; Li, Y.; Xu, J.; Jiang, Y. Antioxidant activities of peel, pulp and seed fractions of common fruits as determined by FRAP assay. J. Nutres. 2003, 23, 1719–1726. [Google Scholar] [CrossRef]
- Yenil, N.; Yemis, F.; Sabikoglu, I.; Memon, N.; Guler, A. Comparative Analyses of Few West Turkish Varieties of Pomegranate (Punica granatum L.) Peels for Phenolic Content Using Liquid Chromatography. Polycycl. Aromat. Compd. 2023, 43, 3941–3957. [Google Scholar] [CrossRef]
- Dschietzig, T.; Richter, C.; Pfannenschmidt, G.; Bartsch, C.; Laule, M.; Baumann, G.; Stangl, K. Dexamethasone inhibits stimulation of pulmonary endothelins by proinflammatory cytokines: Possible involvement of a nuclear factor κB dependent mechanism. Intensive Care Med. 2001, 27, 751–756. [Google Scholar] [CrossRef]
- Bouasla, A.; Barour, C.; Bouasla, I.; Messarah, M. Beneficial effects of Punica granatum L. juice and gallic acid against kidney oxidative damage caused by sodium fluoride. Pharm. Chem. J. 2022, 55, 920–928. [Google Scholar] [CrossRef]
- Khan, M.M.; Yang, W.L.; Brenner, M.; Bolognese, A.C.; Wang, P. Cold-inducible RNA-binding protein (CIRP) causes sepsis-associated acute lung injury via induction of endoplasmic reticulum stress. Sci. Rep. 2017, 7, 41363. [Google Scholar] [CrossRef]
- Husari, A.; Khayat, A.; Bitar, H.; Hashem, Y.; Rizkallah, A.; Zaatari, G.; El Sabban, M. Antioxidant activity of pomegranate juice reduces acute lung injury secondary to hyperoxia in an animal model. BMC Res. Notes. 2014, 7, 664. [Google Scholar] [CrossRef]
- Zhou, G.; Xie, D.; Fan, R.; Yang, Z.; Du, J.; Mai, S.; Xie, L.; Wang, Q.; Mai, T.; Han, Y. Comparison of Pulmonary and Extrapulmonary models of sepsis-associated acute lung injury. Physiol Res. 2023, 72, 741–752. [Google Scholar] [CrossRef]
- Poltorak, A.; Smirnova, I.; He, X.; Liu, M.Y.; Van Huffel, C.; Birdwell, D.; Alejos, E.; Silva, M.; Du, X.; Thompson, P. Genetic and physical mapping of the Lps Locus: Identification of the Toll-4 receptor as a candidate gene in the critical region. Blood Cells Mol. Dis. 1998, 24, 340–355. [Google Scholar] [CrossRef]
- Ciesielska, A.; Matyjek, M.; Kwiatkowska, K. TLR4 and CD14 trafficking and its influence on LPS-induced pro-inflammatory signaling. Cell. Mol. Life Sci. 2021, 78, 1233–1261. [Google Scholar] [CrossRef] [PubMed]
- Kawai, T.; Akira, S. Toll-like receptors and their crosstalk with other innate receptors in infection and immunity. Immunity 2011, 34, 637–650. [Google Scholar] [CrossRef]
- Park, B.S.; Lee, J.O. Recognition of lipopolysaccharide pattern by TLR4 complexes. Exp. Mol. Med. 2013, 45, e66. [Google Scholar] [CrossRef]
- Yu, C.; Wang, D.; Yang, Z.; Wang, T. Pharmacological effects of polyphenol phytochemicals on the intestinal inflammation via targeting TLR4/NF-κB signaling pathway. Int. J. Mol. Sci. 2022, 23, 6939. [Google Scholar] [CrossRef]
- Seyis, F.; Yurteri, E.; Ozcan, A.; Cirak, C. Altitudinal impacts on chemical content and composition of Hypericum perforatum, a prominent medicinal herb. S. Afr. J. Bot. 2020, 135, 391–403. [Google Scholar] [CrossRef]
- Ohkawa, H.; Ohishi, N.; Yagi, K. Assay for lipid peroxides in animal tissues by thiobarbituric acid reaction. Anal Biochem. 1979, 95, 351–358. [Google Scholar] [CrossRef] [PubMed]
- Ellman, G.L. Tissue sulfhydryl groups. Arch. Biochem. Biophys. 1959, 82, 70–77. [Google Scholar] [CrossRef] [PubMed]
- Sung, M.J.; Kim, D.H.; Jung, Y.J.; Kang, K.P.; Lee, A.S.; Lee, S.; Kim, W.; Davaatseren, M.; Hwang, J.T.; Kim, H.J. Genistein protects the kidney from cisplatin-induced injury. Kidney int. 2008, 74, 1538–1547. [Google Scholar] [CrossRef]
- Onaran Acar, B.; Gulendag, E. Comparison of Antimicrobial Activities of Ethanol-and Water-Based Propolis Extracts on Various Foodborne Pathogens by Agar-Well Diffusion Method. Res. Agric. Sci. 2023, 54, 130–136. [Google Scholar]
- CLSI. Performance Standards for Antimicrobial Susceptibility Testing, in Twenty-Fourth Informational Supplement; CLSI, Ed.; Clinical and Laboratory Standards Institute: Wayne, PA, USA, 2020. [Google Scholar]
- Wiegand, I.; Hilpert, K.; Hancock, R.E.W. Agar and broth dilution methods to determine the minimal inhibitory concentration (MIC) of antimicrobial substances. Nat. protoc. 2008, 3, 163–175. [Google Scholar] [CrossRef]
- Bilgehan, H. Klinik Mikrobiyoloji: özel Bakteriyoloji ve Bakteri Enfeksiyonları; Barış Yayınları Fakülteler Kitapevi: İzmir, Türkiye, 1990. [Google Scholar]
- Medeiros, P.; Nga, H.S.; Menezes, P.; Bridi, R.; Balbi, A.; Ponce, D. Acute kidney injury in septic patients admitted to emergency clinical room: Risk factors and outcome. Clin. Exp. Nephrol. 2015, 19, 859–866. [Google Scholar] [CrossRef]
- Bagshaw, S.M.; Uchino, S.; Bellomo, R.; Morimatsu, H.; Morgera, S.; Schetz, M.; Tan, I.; Bouman, C.; Macedo, E.; Gibney, N. Septic acute kidney injury in critically ill patients: Clinical characteristics and outcomes. Clin. J. Am. Soc. Nephrol. 2007, 2, 431–439. [Google Scholar] [CrossRef] [PubMed]
- Bouchard, J.; Acharya, A.; Cerda, J.; Maccariello, E.R.; Madarasu, R.C.; Tolwani, A.J.; Liang, X.; Fu, P.; Liu, Z.; Mehta, R.L. A prospective international multicenter study of AKI in the intensive care unit. Clin. J. Am. Soc. Nephrol. 2015, 10, 1324–1331. [Google Scholar] [CrossRef]
- Centers for Disease Control and Prevention. Antibiotic Resistance Threats in the United States; US Department of Health and Human Services, Centres for Disease Control and Prevention: Atlanta, GA, USA, 2019. [Google Scholar]
- Doostan, F.; Vafafar, R.; Zakeri-Milani, P.; Pouri, A.; Afshar, R.A.; Abbasi, M.M. Effects of pomegranate (Punica granatum L.) seed and peel methanolic extracts on oxidative stress and lipid profile changes induced by methotrexate in rats. Adv. Pharm. Bull. 2017, 7, 269. [Google Scholar] [CrossRef]
- Althunibat, O.Y.; Al-Mustafa, A.H.; Tarawneh, K.; Khleifat, K.M.; Ridzwan, B.H.; Qaralleh, H.N. Protective role of Punica granatum L. peel extract against oxidative damage in experimental diabetic rats. Process Biochem. 2010, 45, 581–585. [Google Scholar] [CrossRef]
- Zeng, Y.; Zhao, H.; Zhang, T.; Zhang, C.; He, Y.; Du, L.; Zuo, F.; Wang, W. Lung-protective effect of Punicalagin on LPS-induced acute lung injury in mice. Biosci. Rep. 2022, 42, BSR20212196. [Google Scholar] [CrossRef]
- Murthy, K.N.C.; Jayaprakasha, G.K.; Singh, R.P. Studies on antioxidant activity of pomegranate (Punica granatum) peel extract using in vivo models. J. Agric. Food Chem. 2002, 50, 4791–4795. [Google Scholar] [CrossRef]
- Shafik, N.M.; El Batsh, M.M. Protective effects of combined selenium and Punica granatum treatment on some inflammatory and oxidative stress markers in arsenic-induced hepatotoxicity in rats. Biol. Trace Elem. Res. 2016, 169, 121–128. [Google Scholar] [CrossRef] [PubMed]
- Wu, X.; Zhang, G.; Hu, X.; Pan, J.; Liao, Y.; Ding, H. Inhibitory effect of epicatechin gallate on protein glycation. Food Res. Int. 2019, 122, 230–240. [Google Scholar] [CrossRef]
- Santos, S.S.; Brunialti, M.K.C.; Rigato, O.; Machado, F.R.; Silva, E.; Salomao, R. Generation of nitric oxide and reactive oxygen species by neutrophils and monocytes from septic patients and association with outcomes. Shock 2012, 38, 18–23. [Google Scholar] [CrossRef]
- Zhang, X.; Dong, S. Protective effects of erythropoietin towards acute lung injuries in rats with sepsis and its related mechanisms. Ann. Clin. Lab. Sci. 2019, 49, 257–264. [Google Scholar] [PubMed]
- Jarrar, D.; Kuebler, J.F.; Rue, L.W.; Matalon, S.; Wang, P.; Bland, K.I.; Chaudry, I.H. Alveolar macrophage activation after trauma-hemorrhage and sepsis is dependent on NF-κB and MAPK/ERK mechanisms. Am. J. Physiol. Lung Cell Mol. Physiol. 2002, 283, 799–805. [Google Scholar] [CrossRef] [PubMed]
- Scheiermann, P.; Hoegl, S.; Hofstetter, C.; Pfeilschifter, J.; Zwissler, B.; Mühl, H.; Boost, K.A.; Scheller, B. Comparing hemodynamics, blood gas analyses and proinflammatory cytokines in endotoxemic and severely septic rats. Int. Immunopharmacol. 2011, 11, 719–723. [Google Scholar] [CrossRef] [PubMed]
- Makled, M.N.; El-Awady, M.S.; Abdel-Aziz, R.R.; Shehab El-Din, A.B.; Ammar, E.M.; Gameil, N.M. Pomegranate extract ameliorates renal ischemia/reperfusion injury in rats via suppressing NF-κB pathway. Hum. Exp. Toxicol. 2021, 40, 573–582. [Google Scholar] [CrossRef]
- Hosseini, A.; Razavi, B.M.; Hosseinzadeh, H. Protective effects of pomegranate (Punica granatum) and its main components against natural and chemical toxic agents: A comprehensive review. Phytomedicine 2023, 109, 154581. [Google Scholar] [CrossRef]





| Observations | Score | ||||
|---|---|---|---|---|---|
| Deterioration of brush border structure in proximal tubules (%) | 0 | 1 | 2 | 3 | 4 |
| none | ≤10% | 10–25% | 26–75% | ≥75% | |
| Debris accumulation in the lumen (%) | none | ≤10% | 10–25% | 26–75% | ≥75% |
| Loss of tubular epithelial cells connections (%) | none | ≤10% | 10–25% | 26–75% | ≥75% |
| Observations | Score | |||
|---|---|---|---|---|
| TNS | 0 | 1 | 2 | 3 |
| none | ≤10% | 10–25% | 26–75% | |
| Hemorrhage | none | ≤10% | 10–25% | 26–75% |
| Atypical Renal Corpuscle | none | ≤10% | 10–25% | 26–75% |
| Compounds | % MeOH | ||
|---|---|---|---|
| 50 | 80 | 100 | |
| Ellagic acid (EA) | 46.385 | 70.971 | 42.306 |
| Gallic acid (GA) | 2.894 | 1.804 | 1.519 |
| Ferulic acid (FA) | 4.427 | 4.075 | 1.726 |
| Quercetin (Q) | 0.789 | 0.818 | 0.812 |
| p-coumaric acid (p-CA) | 0.192 | 0.175 | 0.101 |
| Caffeic acid (CA) | 1.586 | 1.681 | 0.773 |
| 2,4-dihydroxybenzoic acid (2,4-DHBA) | 11.193 | 11.538 | 9.934 |
| Epigallocatechin gallate (EGCG) | 186.88 | 274.901 | 191.394 |
| Catechin hydrate (CH) | 5.674 | 5.488 | 5.399 |
| Caffeine (CAF) | 16.328 | 21.708 | 7.547 |
| Chlorogenic acid (CGA) | 60.394 | 28.480 | 21.575 |
| Ursolic acid (UA) | 2.44 | 3.380 | 10.719 |
| Punicalagin (A) (PUN) | 4528.030 | 1451.663 | 1345.471 |
| Punicalagin (B) (PUN) | 2591.466 | 827.183 | 639.108 |
| Groups | TBARS (nmol/g Tissue) | GSH (µmol/g Tissue) |
|---|---|---|
| Control | 115 ± 13 | 7.93 ± 0.85 |
| LPS | 223 ± 51 b | 10.63 ± 2.47 a |
| PGPE100 | 147 ± 35 | 8.70 ± 1.04 |
| PGPE300 | 146 ± 17 | 8.85 ± 1.69 |
| Groups | Brush Border Damage Score | Luminal Debris Accumulation Score | Loss of Tubular Epithelial Cells Score | TNS |
|---|---|---|---|---|
| Control | 0 (0–0.5) | 0 (0–0) | 0 (0–0) | 0 (0–0.5) |
| LPS | 2.5 (2–3) a | 2 (1–2) a | 3 (2–3) a | 7.5 (5–8) a |
| PGPE100 | 1 (0–1) b | 0 (0–0.5) b | 0.5 (0–0.5) b | 1.5 (0.5–2) a,b |
| PGPE300 | 0.5 (0–0.5) b | 0 (0–0.5) b | 0 (0–0.5) b | 1 (0.5–1) a,b |
| Group | TLR4 Positivity Scores | NF-κB/p65 Positivity Scores |
|---|---|---|
| Control | 0 (0–0.5) | 0 (0–0) |
| LPS | 1.5 (1–2) a | 3 (2–3) a |
| PGPE100 | 0.5 (0–0.5) b | 0 (0–1) b |
| PGPE300 | 0.5 (0–0.5) b | 0 (0–0.5) b |
| Bacteria | Zone Diameter (mm) | MIC (µg/mL) | Appearance in Plate | ||
|---|---|---|---|---|---|
| Antibiotics | PGPE (200 mg/mL) | ||||
| A. baumannii | CAZ | - | 27 | 8 |  |
| CIP | - | ||||
| AMK | 12 | ||||
| MER | 10 | ||||
| E. coli | CAZ | 30 | 21 | 32 |  |
| CIP | 43 | ||||
| AMK | 27 | ||||
| AMP | 21 | ||||
| P. aeruginosa | CAZ | 26 | 20 | 16 | |
| CIP | 40 | ||||
| AMK | 30 | ||||
| TZP | 28 | ||||
Disclaimer/Publisher’s Note: The statements, opinions and data contained in all publications are solely those of the individual author(s) and contributor(s) and not of MDPI and/or the editor(s). MDPI and/or the editor(s) disclaim responsibility for any injury to people or property resulting from any ideas, methods, instructions or products referred to in the content. |
© 2024 by the authors. Licensee MDPI, Basel, Switzerland. This article is an open access article distributed under the terms and conditions of the Creative Commons Attribution (CC BY) license (https://creativecommons.org/licenses/by/4.0/).
Share and Cite
Sahin Aktura, S.; Sahin, K.; Tumkaya, L.; Mercantepe, T.; Topcu, A.; Pinarbas, E.; Yazici, Z.A. The Nephroprotective Effect of Punica granatum Peel Extract on LPS-Induced Acute Kidney Injury. Life 2024, 14, 1316. https://doi.org/10.3390/life14101316
Sahin Aktura S, Sahin K, Tumkaya L, Mercantepe T, Topcu A, Pinarbas E, Yazici ZA. The Nephroprotective Effect of Punica granatum Peel Extract on LPS-Induced Acute Kidney Injury. Life. 2024; 14(10):1316. https://doi.org/10.3390/life14101316
Chicago/Turabian StyleSahin Aktura, Sena, Kazim Sahin, Levent Tumkaya, Tolga Mercantepe, Atilla Topcu, Esra Pinarbas, and Zihni Acar Yazici. 2024. "The Nephroprotective Effect of Punica granatum Peel Extract on LPS-Induced Acute Kidney Injury" Life 14, no. 10: 1316. https://doi.org/10.3390/life14101316
APA StyleSahin Aktura, S., Sahin, K., Tumkaya, L., Mercantepe, T., Topcu, A., Pinarbas, E., & Yazici, Z. A. (2024). The Nephroprotective Effect of Punica granatum Peel Extract on LPS-Induced Acute Kidney Injury. Life, 14(10), 1316. https://doi.org/10.3390/life14101316








